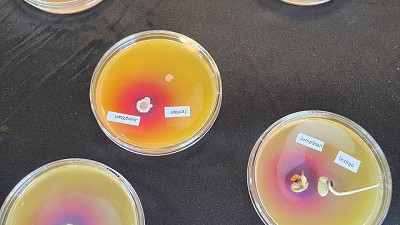
Una nueva combinación de microorganismos incrementa en 200 kilos el rendimiento de soja frente a la inoculación tradicional.

Con un enfoque comprometido con el medio ambiente, Agro Sustentable participó con tres stands en La Rural en el marco de la edición número 32 del Congreso Aapresid. La empresa de capitales nacionales destaca por su experiencia en la investigación, fabricación y comercialización de insumos 100% orgánicos.

En la feria mostraron los avances más importantes de los últimos años, exhibieron su catálogo de bioinsumos y contaron cómo es su metodología de producción sostenible. Además de sortear un drone entre los que se acercaron a los puestos, también dieron a conocer algunos detalles de su lanzamiento: una aplicación móvil que gracias a la utilización de inteligencia artificial (IA) facilita el trabajo de los productores.
Se trata de una app en donde la agilidad del servicio es una de sus principales características. El productor sólo tiene que bajarla en su celular, ingresar algunos datos básicos de sus cultivos y marcar los días en el calendario digital en los que planea realizar la aplicación. Inmediatamente la aplicación aportará una información precisa sobre los cultivos y posibles bioinsumos a aplicar, además de apoyar prácticas agrícolas respetuosas con el medio ambiente.

“La IA permitirá tomar los datos de meteorología para que los productores obtengan la mejor recomendación para la aplicación de los bioinsumos”, declaró Matías Imperiale, Director Operativo de la empresa. El servicio está siendo desarrollado por la división Agro-Tech de Agro Sustentable, el área de negocios especializada en brindar servicios y soluciones de tecnologías innovadoras para la maximización productiva sostenible.
“Nuestro diferencial está en la tecnología, la innovación y la sustentabilidad, una combinación de factores que nos permite ganar nuevos mercados a nivel regional e internacional”, agregó Imperiale, reforzando que la incorporación de herramientas de IA en una app “le hará cada vez más fácil el trabajo a los productores”. En ese sentido, manifestó también que “hoy es posible obtener ganancias y ser responsables con el cuidado del medio ambiente” y considera que “sólo es cuestión de tiempo para que la incorporación total de prácticas sostenibles aplicadas al agro sea una realidad”.

En cuanto al área de Agro-Tech, la empresa ya trabajaba con la utilización de drones agrícolas, un servicio que les permitió llegar recientemente a España. “Las ventajas de los drones son varias y se conectan en simultáneo, pero una de sus características más destacadas es la optimización de utilización del uso del agua, usando menos recursos y generando un impacto positivo”, resaltó Imperiale.
Las aplicaciones agrícolas realizadas con drones estiman un ahorro del 90% del uso de agua y puede ahorrar entre un 30% y 50% del uso de fitosanitarios. La experiencia tecnológica y el enfoque sostenible fueron pilares claves en la inserción de sus servicios al mercado europeo, un destino cada vez más regulado por sus normativas sustentables.

La llegada de Agro Sustentable a España, como también a Paraguay, significaron verdaderos hitos recientes para la firma, pero su expansión en Argentina también viene en alza. Con su planta de biotecnología en la provincia de Misiones, sus productos son distribuidos por todo el país. En Mendoza, por caso, acaban de ser reconocidos por WIPO GREEN, un programa de la Organización de las Naciones Unidas (ONU) que busca promover la innovación y la tecnología a nivel global.
En este contexto, la empresa se inserta como un actor de relevancia dentro de la cadena de valor del esquema agroindustrial argentino. Su signo diferencial es la propuesta de una agricultura rentable, responsable y sustentable, tres pilares que destacan también en su certificación de Empresa B, siendo una de las 234 compañías que cuentan con dicha certificación en el país. La certificación garantiza estándares en desempeño social, económico y ambiental, un triple impacto positivo que también fue reconocido por Marina Arias, Directora Ejecutiva de Empresas B que participó del evento de la compañía.

“La certificación B no es un punto de llegada, sino un hito en su camino de triple impacto, en el que se comprometen a medir, comunicar y mejorar el impacto socio-ambiental de sus operaciones”, subrayó Arias en el encuentro con periodistas. En ese camino de reconversión a una economía que se adapte a las necesidades medioambientales que existen en los mercados desarrollados, la firma busca seguir creciendo y mostrar el camino de una agricultura sostenible.
“Entendemos que cada aspecto de nuestra operación se interconecta con otro y que la sustentabilidad es el hilo conductor que une todos estos elementos. Cultivamos el futuro, nuestro objetivo es transformar el sector agropecuario de nuestro país a través de la innovación”, resumió Imperiale. Así como lo expresa el directivo, la empresa reafirma a diario su compromiso con el cuidado del ambiente. Su premisa fundante es que un modelo de negocios resiliente y responsable es la única vía posible para crecer en armonía con nuestro planeta.
Para más información ingresá a: www.agrosustentable.com